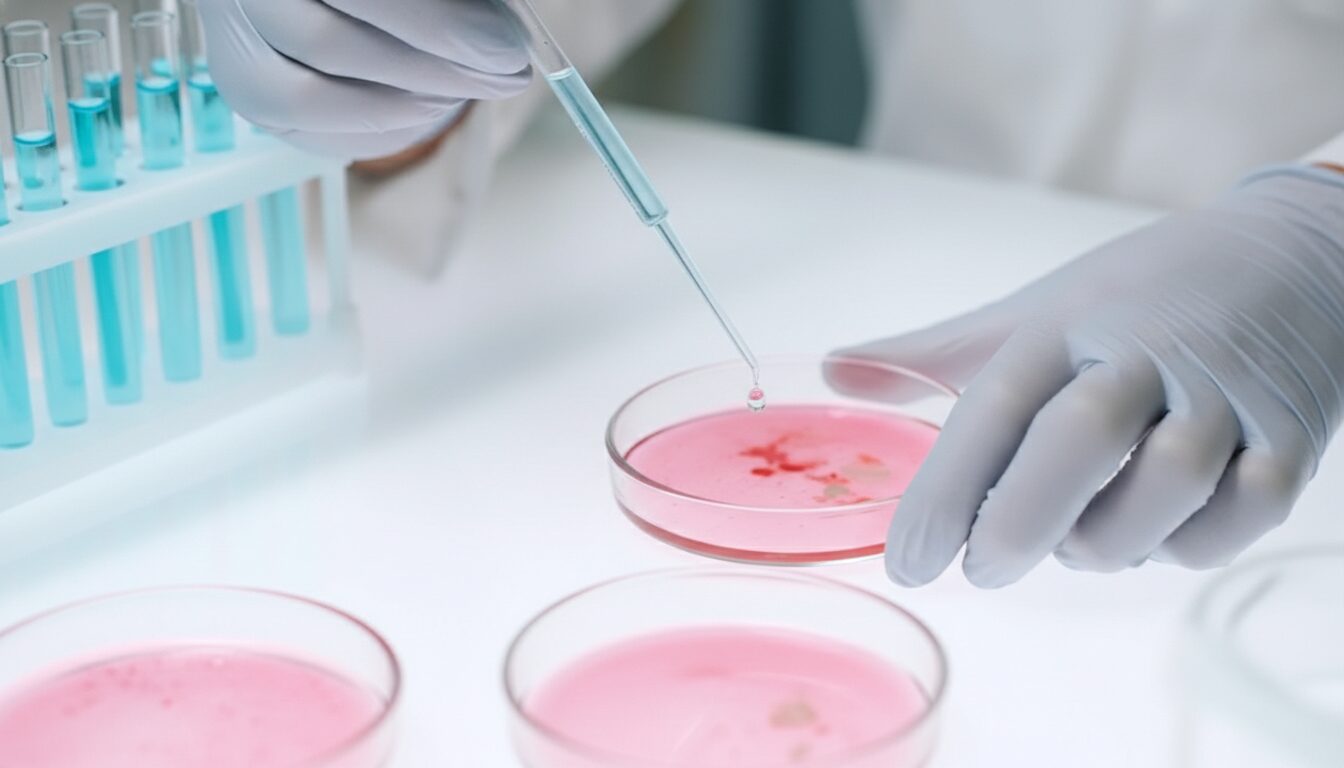
14000例。選ばれ続ける当院の再生医療の秘密。

14000例。選ばれ続ける当院の再生医療の秘密。
皆さん、こんにちは。
再生医療に携わって、早いもので8年が経ちました。
振り返ってみると、当法人ではおかげさまで14,000例もの患者様に治療を受けていただくことができました。言葉で説明するより、これだけ多くの患者様に選んでいただけたこと、それこそが答えだと思います。
患者様との何気ない会話から
先日、ある患者様が幹細胞の点滴を受けられている時のことです。
点滴をじっと見ながら、「先生、これって本当に大丈夫なんですか?」と不安そうに聞かれました。
初めて再生医療を受けられる方は、やはり不安があるのは当然のことです。私は患者様の目を見ながら、こうお答えしました。
「そうですよね、初めてだと不安になりますよね。でもね、これ、患者様ご自身の細胞なんですよ。患者様の脂肪から採って、丁寧に培養したものなんです。だから体にとっては『帰ってきた仲間』みたいなものなんですね。だからとても安全なんですよ。」
そう説明させていただくと、患者様は少しホッとした表情になられました。
その後、患者様が改めて点滴の様子をじっと見ながら、
「あれ、なんか…お水みたいですね」とポツリと仰ったんです。

「確かに、幹細胞の点滴液は透明で、見た目は本当に水のように見えますよね。でも、その中には何億個もの生きた幹細胞が入っていて、体の中で損傷した組織を修復してくれるんですよ。」
私がそう説明すると、患者様は点滴をじっと見つめながら、「こんなに透明なのに、すごい力があるんですね…なんだか不思議で神秘的です。」と笑顔で仰いました。
こういった何気ない会話の中に、患者様の素直な気持ちや驚きが表れていて、私たちも日々勉強させていただいています。
信頼していただけることの重さ
紹介でいらっしゃる患者様が多いということは、それだけ治療に満足していただけた証だと思っています。
「母がひざの痛みで悩んでいて…」「知人から聞いたのですが…」
そんな風に、大切なご家族やお知り合いを紹介してくださる。これほど嬉しいことはありません。
また、当院の再生医療に魅力を感じて、各分野の専門の先生方が仲間に加わってくれていることも、私にとって大きな励みになっています。整形外科、内科、脳神経外科など、それぞれの分野で豊富な経験を積んでこられた先生方が、「この治療なら患者さんを本当に良くできる」と感じて、当院を選んでくださっています。
我々医療に携わる医師だからこそ、見えてくるものがあります。幹細胞の質へのこだわり、細部まで計算された培養方法、長年の経験から生まれた独自の投与技術、そして毎日欠かさず院内カンファレンスでの議論、こうした日々の積み重ねが、患者様の身体に現れる確かな治療効果となっています。専門家の先生方は、そうした表面には出てこない部分まで正確に評価してくださいます。「ここでなら、本当に患者さんのためになる医療ができる」。そう確信して、リペアセルクリニックで共に再生医療に取り組んでいます。この信頼の連鎖こそが、再生医療の真の発展を支えていると、私は確信しています。
これからも
再生医療は、今、世界中で注目されている医療分野です。ニュースでも取り上げられ、2025年の大阪・関西万博でも大きなテーマとして掲げられるなど、医療の未来を変える治療として世界的に飛躍的な広がりを見せています。
これからも、一人でも多くの方に「再生医療を受けてよかった」と思っていただけるよう、私たち医師はもちろん、スタッフ一同共に、日々精進してまいります。
再生医療医師監修:坂本貞範
Warning: Undefined variable $taxonomy_slug in /home/xb684686/fuelcells.org/public_html/wp/wp-content/themes/uniontheme/single-voice.php on line 46




